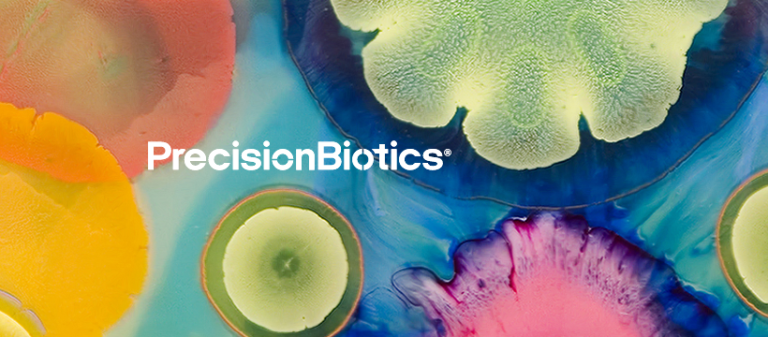

Working with The Content Marketing Team is always pleasure. The team really understood our brand and tone of voice from the outset and have been producing incredible blog and email content for us this year. Our industry has strict regulatory requirements which can really hinder the content we create, but the team have taken this in their stride and still continue to create engaging search engine optimised content within these constraints. I would absolutely recommend them to anyone with content creation needs going forward.
Andrea Bent, Sr. Digital Marketing Specialist
Novozymes U.K. Ltd.
PrecisionBiotics® develops clinically-proven natural supplements which provide one-in-a-trillion solutions to many modern health problems.
Its mission is to unlock and share the natural power of the human microbiome and empower people to take control of their health and over the last 25 years, it has researched probiotic cultures and enzymes and their impact on the human microbiome, identifying unique bacterial strains which target specific health conditions, such as IBS and stress.
PrecisionBiotics products are clinically tested, backed by data and validated to the highest scientific standards.
Creating engaging content in a highly regulated field
PrecisionBiotics approached The Content Marketing Team to help generate content which would engage and educate its chosen demographic whilst remaining compliant with a myriad of UK and European laws about nutritional and health claims.
Fortunately The Content Marketing Team has significant experience of working within tightly regulated fields, where every article we produce is thoroughly researched and properly referenced before being reviewed by legal and regulatory teams.
Since 2021, we have been crafting monthly blog content along with supporting email marketing content on topics such as ‘Menopause, Mood, and the Gut: The Gut Brain Axis’ Impact on Your Menopause’; ‘The Benefits of Fermented Foods; What Do They Do For Your Gut?’ And ‘Brain Supplements for Healthy Cognitive Function.’